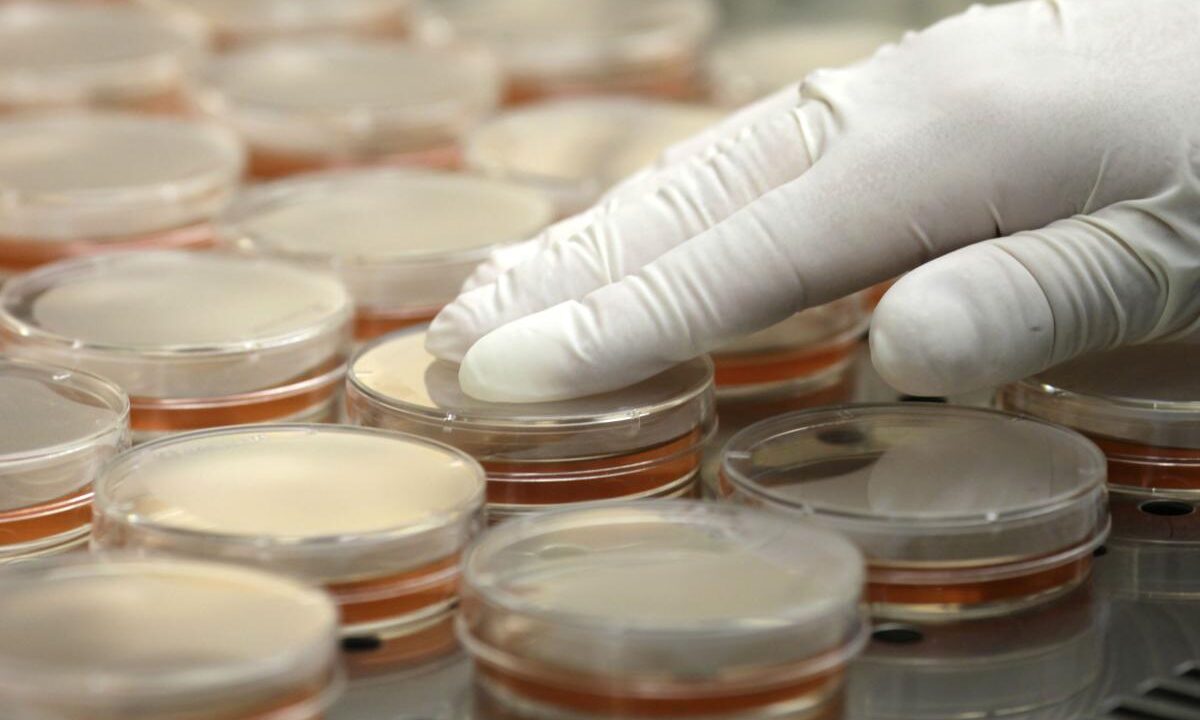

Emergency Vehicle Sanitization & Deodorization
Ambulances | Police Cars| Fire Trucks | Utility Vans | Paramedic Vehicles | Hazmat Trucks | Firefighting Gear & Equipment | Bullet Proof Vests These types of vehicles and Personal Protective Gear (PPE) are “Hot Beds” for bacteria, germs, viruses and allergens. Normal cleaning may keep these microorganisms in check, but right now, nothing is…